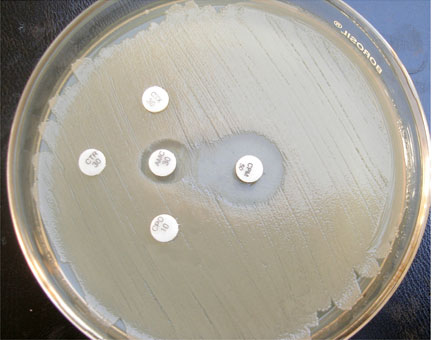
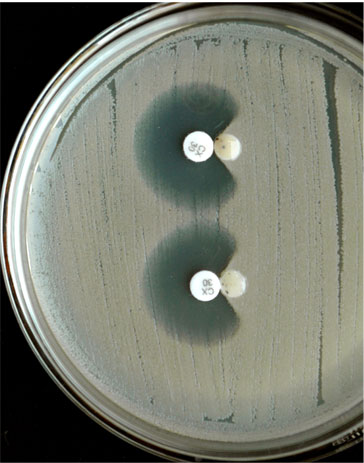

Modified Double Disc Synergy Test to Detect ESBL Production in Urinary Isolates of Escherichia coli and Klebsiella pneumoniae
Jaspal Kaur1, Shashi Chopra2, Gomty Mahajan4
1 Conducted the Reseach Work, Data Analysis and Iterpretation, Drafted the Article.
2 Helped the Research and Drafting of the Article.
3 Data Analysis and Interpretation, Edited the Article.
4 Data Analysis and Interpretation, Edited the Article.
NAME, ADDRESS, E-MAIL ID OF THE CORRESPONDING AUTHOR: Dr. Jaspal Kaur, Assistant Professor, Department of Microbiology, Punjab Institute of Medical Sciences, Jalandhar 144001, Punjab, India.
Phone: 8699835982
E-mail: jasmicro@rediffmail.com
Background and Objectives: Various phenotypic methods are recommended in the routine practice to detect the ESBL production in gram negative bacilli. Among them, the Double Disc Synergy Test (DDST) which uses the third generation cephalosporins (3GC), is a simple and a reliable method. But the coexistence of AmpC may give false negative results. In such cases, the ESBL detection can be improved by using cefepime along with the third generation cephalosporins in DDST.
Methods: A total of 350 urinary isolates (224 Escherichia coli and 126 Klebsiella pneumoniae) were studied for ESBL production by the modified double disc test (MDDST) i.e. by using cefotaxime, ceftriaxone, cefpopdoxime (third generation cephalosporins) and cefepime ( fourth generation cephalosporin) along with a amoxicillin-clavulanate disc.
Results and Interpretation: ESBL production was seen in 63.4% (142/224) Escherichia coli and in 60.3% (76/126) Klebsiella pneumoniae isolates by MDDST. Among these, in twelve E.coli and five K.pneumoniae strains, only cefepime but none of the third generation cephalosporins showed synergism with amoxicillin-clavulanate. All these seventeen strains showed a clear extension of the edge of inhibition which was produced by cefepime towards the amoxicillin-clavulanate disc. These strains were further tested for AmpC co-production by the AmpC disc test and all these strains were found to be AmpC positive, thus revealing the superior activity of cefepime in detecting ESBLs in the bacteria which co-produced AmpC. A high degree of coresistance was found in the ESBL producers.
Conclusion: The ESBL detection can be improved by MDDST by using cefepime along with the third generation cephalosporins.
Antimicrobial resistance, ESBL, Modified double disc synergy test
INTRODUCTION
The Extended Spectrum β-Lactamases (ESBLs) are typically plasmid-mediated enzymes that hydrolyze the penicillins, the third generation cephalosporins and aztreonam [1]. They are not active against the cephamycins (cephoxitin and cefotetan), but are susceptible to β-the lactamase inhibitors (clavulanic acid). The ESBL phenotypes have become more complex due to the production of multiple enzymes which include the inhibitor-resistant ESBL variants and plasmid-borne AmpC, the production of ESBLs in AmpC producing bacteria, the production of ESBLs in the KPC (Klebsiella pneumoniae Carbapenemase) producing bacteria, enzyme hyperproduction and porin loss [2,3]. These enzymes have spread worldwide and their prevalence varies by the geographical area. The extended spectrum β-lactamases often remain undetected by the current isolation and susceptibility methods. Molecular methods are the key tools for their detection but the facilities for them are not available in most of the laboratories, especially in the developing countries.
The clinical microbiological tests which are used for detecting ESBLs employ a β-lactamase inhibitor, usually clavulanate, in combination with the Third Generation Cephalosporins (3GC) such as ceftriaxone, ceftazidime or cefotaxime [4]. Recently, the coexistence of both AmpC and ESBLs in some gram negative organisms has been reported [3,5]. The AmpC β-lactamases are the cephalosporinases that are poorly inhibited by clavulanic acid and they can be differentiated from ESBLs by their ability to hydrolyze the cephamycins [6].
Such strains with the co-existing AmpC β-lactamases may give false negative tests for the detection of ESBLs, because clavulanic acid which is used in the standard DDST test for the ESBL detection acts as an inducer of the high level AmpC production and it leads to the resistance to the 3rd generation cephalosporins as well as to the 3rd generation cephalosporins + clavulanic acid. So, even if ESBL is present, it will not be detected and it may result in a false negative test. A modification in the original double disc synergy test i.e the Modified Double Disc Synergy Test (MDDST) with the use of the 4th generation cephalosporins (cefepime) and an optimum spacing of drugs for the detection of the synergy, depending on the zone of inhibition which is obtained with an extendedspectrum cephalosporin disc in a particular isolate, can improve the detection of ESBL in the strains which co-produce AmpC. A high–level AmpC production has a minimal effect on the activity of cefepime, thus making this drug a more reliable detection agent for ESBLs in the presence of an AmpC β-lactamase [7]. Tzelepi et al. reported a sensitivity of 16% only when the cefotaxime, ceftriaxone, ceftazidime and the aztreonam disks were used. The use of cefepime increased the sensitivity of the test to 61%, when the disk was placed at a standard distance (30 mm) from the clavulanate-containing disk. The sensitivity increased even more, to 90%, when this distance was reduced to 20 mm [8]. The present study was therefore undertaken to evaluate the prevalence of the extended spectrum β-lactamase (ESBL) producing strains of Escherichia coli and Klebsiella pneumoniae in the urinary isolates at our tertiary care hospital by using the Modified Double Disc Synergy Test (MDDST).
MATERIALS AND METHODS
This study was conducted in the Department of Microbiology, Punjab Institute of Medical Sciences, Jalandhar, Punjab, India. A total of 350 isolates of Escherichia coli (224) and Klebsiella pneumoniae (126) which were obtained over a period of one year from January 2011 to December 2011, from patients with significant bacteruria, were identified, based on the colony morphology and the biochemical reactions. The clinico-demographic data of the study patients was noted. The Chi-square test was used to analyze the susceptibility pattern of the non β-lactam antibiotics in the ESBL producers and non-producers.
Antimicrobial Susceptibility Testing
The isolates were tested for their antimicrobial susceptibilities by the disc diffusion method according to the CLSI guidelines [8]. The following antibiotics were used; cefotaxime (30μg), cefpodoxime (30μg),ceftrioxone (30μg), ceftazidime (30μg), cefepime (30μg), cephoxitin (30μg), gentamicin (10μg), amikacin (30μg), ciprofloxacin (5μg), norfloxacin (10μg), nitrofurantoin (100μg), cotrimoxazole (25μg), piperacillin/tazobactam(100/10μg), meropenem (10μg), and imipenem (10μg). All the antibiotic discs were procured from Hi-media, Mumbai.
Testing for the ESBL Production
All the strains which showed a diameter of less than 27mm for cefotaxime and less than 25mm for ceftriaxone, were selected for checking the ESBL production. The ESBL production was tested by the Modified Double Disc Synergy Test (MDDST) by using a disc of amoxicillin-clavulanate (20/10 μg) along with four cephalosporins; 3GC-cefotaxime, ceftriaxone, cefpodoxime and 4GC-cefepime. A lawn culture of the organisms was made on a Mueller-Hinton agar plate, as was recommended by CLSI [9]. A disc which contained amoxicillin-clavulanate (20/10 μg) was placed in the centre of the plate. The discs of 3GC and 4GC were placed 15mm and 20mm apart respectively, centre to centre to that of the amoxicillin-clavulanate disc [10]. Any distortion or increase in the zone towards the disc of amoxicillin-clavulanate was considered as positive for the ESBL production. Klebsiella pneumoniae 700603 was used as a control strain for a positive ESBL production and Escherichia coli 25922 was used as a negative control for the ESBL production.
All the isolates which showed a synergistic effect with cefepime only in MDDST were further tested for the AmpC enzyme production by AmpC disc test after an initial screening with a cephoxitin (30 μg) disc. A lawn culture of a 0.5 McFarland’s suspension of ATCC E.coli 25922 was prepared on a Mueller-Hinton agar plate. A 30 μg cephoxitin disc was placed on the inoculated surface of the agar. A sterile plain disc (6mm) which was inoculated with several colonies of the test organism was placed beside the cephoxitin disc, almost touching it. After an overnight incubation at 37°C, the plates were examined for either an indentation or a flattening of the zone of inhibition, which indicated the enzyme inactivation of cephoxitin (positive result), or an absence of distortion, which indicated no significant inactivation of cephoxitin (negative result).
RESULTS
Of the 350 isolates which were studied, 62.3% (218/350) were found to be ESBL producers by MDDST. ESBL production was seen in 63.4% (142/224) Escherichia coli and in 60.3% (76/126) Klebsiella pneumoniae isolates. Among these, in twelve E.coli and five K.pneumoniae strains, only cefepime but none of the third generation cephalosporins showed synergism with amoxicillinclavulanate [Table/Fig-1]. All these seventeen strains showed a clear extension of the edge of inhibition which was produced by cefepime, towards the amoxicillin-clavulanate disk. [Table/Fig-2] The AmpC disk test was positive in all of these seventeen isolates [Table/Fig-3]. Eighty three percent (181/218) of the ESBL producers were from in-patients. These ESBL isolates were obtained from 90 male and 128 female patients, with a male female ratio of 1:1.4. They were distributed in the age group of 1year to 90 years. A false susceptibility to various β-lactam antibiotics was observed in the ESBL producers, the maximum susceptibility being to ceftazidime (13%) [Table/Fig-4]. A co-resistance to the non-β lactam antibiotics was observed more (p<0.01) with the ESBL producers [Table/Fig-5]. The resistance to amikacin and nitrofurantioin was comparatively less (17.4% and 13.3% respectively). Seventeen out of the 218 ESBL producing strains showed resistance to the combination drug, piperacillin/tazobactam. A resistance to the carbepenems is also emerging. The resistance to meropenem was observed to be more (6.0%) as compared to that to imepenem (3.2%).
ESBL and AmpC production in Escherichia coli & Klebsiella pneumoniae isolates.
| Organism | Total ESBL producers* | ESBL+ AmpC Co-producers** | Pure ESBL producers |
|---|
| E.coli (n=224) | 142 (63.4%) | 12 (5.4%) | 130 (58.0%) |
| K. pneumoniae (n=126) | 76 (60.3%) | 5 (4%) | 71 (56.3%) |
| Total (n=350) | 218 (62.3%) | 17 (4.9%) | 201 (57.4%) |
Clavulanate synergy with either 3GCs or 4GC.
Clavulanate synergy with only 4GC (cefepime) and none of 3GCs
MDDST showing synergism of only cefepime but none of the 3 GC used with amoxicillin-clavulanate. (AMC–Amoxyclav, CTRCeftriaxone, CTX-Cefotaxime, CPD-Cefpodoxime, CPM- cefipime)
Positive AmpC test (indentation of the zone of inhibition around cephoxitin disc)
In vitro susceptibility of ESBLs to β-lactam antibiotics
| Antibiotics | E. coli (n=142) | K.pneumoniae (n=76) | Total (n=218) |
|---|
| Ceftazidime | 17 | 11 | 28(13%) |
| Cefotaxime | 12 | 8 | 20 (9%) |
| Cefpodoxime | 0 | 0 | 0 (0%) |
| Ceftriaxone | 3 | 4 | 7 (3%) |
| Ccefepime | 6 | 5 | 11(5%) |
Antibiotic susceptibility of ESBL producers and non Producers to non β-lactam various antibiotics
| Antibiotics | ESBL producers (n=218) Susceptible No. % | Non-producers (n=132) Susceptible No. % |
|---|
| Norflox | 15 6.9* | 77 58.3 |
| Ciprofloxacin | 22 10.1* | 85 64.4 |
| Amikacin | 180 82.6 | 122 92.4 |
| Gentamicin | 48 22.0* | 114 86.4 |
| Co-trimoxazole | 39 17.9* | 58 43.9 |
| Nitrofurantoin | 189 86.7 | 125 94.7 |
| Piperacillin/Tazobactum | 201 92.2 | 132 100 |
| Meropenem | 205 94.0 | 132 100 |
| Imipenem | 211 96.8 | 132 100 |
p<0.01
DISCUSSION
The prevalence of ESBLs among the clinical isolates vary greatly world wide and in geographical areas and it is rapidly changing over time. In the west, the ESBL production in Enterobacteriaceae varies from 5 to 52 per cent and in other Asian countries, it varies from 10 to 46.5 per cent10 [9,12]. Other studies from India have reported a high prevalence of the ESBL production, which ranges from 41.0 to 63.6 per cent in E. coli and 40 to 83.3 per cent in K. pneumoniae [13–15]. ESBLs constitute a serious threat to the β-lactam therapy. Due to the difficulty in their detection by the current clinical methods, many of these strains have been falsely reported to be susceptible to the widely used broad-spectrum β-lactams [16]. The ESBL producers are intrinsically resistant to all the cephalosporins even if they exhibit an in vitro susceptibility [17]. In our study, false susceptibilities to ceftazidime and cefotaxime were observed in 13% and 9% of the ESBL producers. This could be due to the reason that the optimal substrate profile varies from one ESBL enzyme to another [18]. Hence, the susceptibility panels with only one extended spectrum cephalosporin cannot predict the resistance to the other extended spectrum cephalosporins [19]. The ESBL production coexists with the resistance to several other antibiotics. The ESBLs are encoded by plasmids which also carry resistant genes for other antibiotics [20]. A co-resistance to the quinolones and the aminoglycosides is common [21]. We found such an associated resistance with co-trimoxazole (82.1%), gentamicin (78%) and the flouroquinolones (90-93%). Varsha et al reported 91.17%, 100% and 94.91% resistances respectively to gentamicin, cotrimoxazole and ciprofloxacin in the ESBL producers [22]. The high resistance to the non β-lactam antibiotics of the ESBL producing strains poses a threat of treatment failure by these drugs and it also minimizes the therapeutic choice to the carbapenems. Hence, the emerging resistance to the carbepenems is a phenomenon of great concern for combating the infections of the multidrug resistant bacteria [23]. Although β- lactam/ β- lactamase inhibitor combinations have been suggested as the treatment option for ESBL producers, these drugs must be given in high doses [24].
The ESBL testing in the AmpC-producing species of Enterobacteriacae is an unresolved issue. In the presence of AmpC, along with ESBL in the gram negative organisms, the DDST may not show positivity, as the AmpC type of β-lactamase inhibits the action of clavulanate. Hence, it obscures the synergistic effect of clavulanic acid and the 3GCs which are used. The possible approaches for overcoming the difficulty in the ESBL detection in the presence of AmpC include the use of tazobactam or sulbactam, which are much less likely to induce the AmpC β-lactamases and are therefore the preferable inhibitors of the ESBL detection tests with these organisms or testing cefepime as an ESBL detection agent [6]. Cefepime, a fourth –generation cephalosporin, is a more reliable detection agent for ESBLs in the presence of the AmpC β-lactamases, as this drug is stable to AmpC β-lactamase. Thus, it will demonstrate the synergy which arises from the inhibition of ESBL by clavulanate in the presence of the AmpC enzyme. Previously, Tzouvelekis et al and Tzelepi et al., had reported that the use of cefepime had increased the sensitivity of DDST with the extended spectrum cephalosporins for the detection of ESBLs in Klebsiella pneumoniae and the Enterobacter species respectively [25,8]. In another study, the performance of a Modified Double- Disk Test (MDDT) which utilized cefotaxime, ceftazidime, cefepime and aztreonam along with a amoxicillin-clavulanate disk, was evaluated for the detection of ESBLs in the clinical isolates of E.coli and K.pneumoniae [26]. Of the 136 isolates, 112(82%) and 102(75%) were positive for ESBL by the MDDT and the NCCLS/ CLSI methods respectively. Ten (7.4%) isolates (eight E.coli and two K.pneumoniae), all of which were positive for ESBL by MDDT, yielded negative results with the NCCLS/CLSI disk method [26]. In another study, two K. pneumoniae isolates out of 100 consecutive isolates of E. coli and Klebsiella, were positive by the double-disk synergy test for ESBL with cefepime only, but not with any of the other third-generation cephalosporins which were used [22]. A study of MKR Khan et al had similar findings, in which DDST was positive in 25/40 isolates and MDDST was positive in 40/40 isolates [27]. Mohanty et al evaluated the performance of the cefepime/ cefepime-clavulanate ESBL E test for detecting the ESBL production in E.coli, K.pneumoniae and P.mirabilis, which detected the maximum number of isolates (70/113, 61.9%) as ESBL positive as compared to the ceftazidime/ceftazidime-clavulanate and the cefotaxime/cefotaxime-clavulanate strips, which detected 57 (50.4%) isolates each as ESBL positive. In the 66 (58.4%) isolates that co-produced AmpC, in addition to the ESBL enzymes, the cefepime/cefepime-clavulanate E test strip detected ESBLs in an additional 13(11.4%) isolates as compared to the other ESBL E test strips [3]. More recently. Dhara et al demonstrated the superiority of MDDST over DDST for the ESBL detection [28]. So, 4GCcefepime has been recommended as an alternative cephalosporin for the ESBL detection in the presence of AmpC. In our study, we used both 3GC and 4 GC in MDDST. 4 GC-Cefepime helped in detecting seventeen additional strains as ESBL producers, which otherwise would have gone undetected with the use 3GC alone, as in the original double disc synergy test.
CONCLUSION
The frequency of the ESBL production can easily be underestimated in the clinical isolates of Escherichia coli and Klebsiella pneumoniae with the use of the current CLSI [10] recommended methods, since these organisms often produce multiple β-lactamases. In such situations, where the AmpC β-lactamases can interfere with the clavulanate synergy, the application of the double disc synergy tests that combine amoxicillin-clavulanate with cefepime, may increase the possibility of the ESBL detection. An optimum identification of the ESBL producing isolates is essential to formulate policies for an empirical antimicrobial therapy, especially in high-risk units where the infections which are caused by these organisms are common. It also helps in monitoring the development of antimicrobial resistance and in the implementation of proper hospital infection control measures.
*Clavulanate synergy with either 3GCs or 4GC.
**Clavulanate synergy with only 4GC (cefepime) and none of 3GCs
*p<0.01
[1]. Pfaller MA, Segreti J, Overview of the epidemiological profile and laboratory detection of extended spectrum β-lactamasesClin Infect Dis 2006 42:S153-S163. [Google Scholar]
[2]. Tsakris A, Poulou A, Themeli-Digalaki K, Voulgari E, Pittarais T, Sofianou D, Use of boronic acid disk tests to detect extended spectrum β-lactamases in clinical isolates of KPC Carbapenemase possessing EnterobacteriaceaeJ Clin Microbiol 2009 47:3420-26. [Google Scholar]
[3]. Mohanty S, Gaind R, Ranjan R, Deb M, Use of the cefepime-clavulanate ESBL test for detection of extended-spectrum beta-lactamases in AmpC co-producing bacteriaJ Infect Dev Ctries 2010 4(1):024-29. [Google Scholar]
[4]. Chaudhary U, Aggarwal R, Extended spectrum β-lactamases (ESBL)- An emerging threat to clinical therapeuticsIndian J Med Microbiol 2004 22(2):75-80. [Google Scholar]
[5]. Song W, Bae IK, Lee YN, Lee CH, Lee SH, Jeong SH, Detection of extended spectrum β-lactamases by using boronic-acid as an AmpC β-lactamase inhibitor in clinical isolates of Klebsiella spp. and Escherichia coliJ Clin Microbiol 2007 45:1180-84. [Google Scholar]
[6]. Manchanda V, Singh NP, Occurrence and detection of AmpC β-lactamases among gram negative clinical isolates using a modified three-dimensional test at Guru Tegh Bhadur Hospital, Delhi, IndiaJ Antimicrob Chemother 2003 51:415-18. [Google Scholar]
[7]. Thomson KS, Controversies about extended spectrum and AmpC β-lactamasesEmerg Infect Dis 2001 7:333-36. [Google Scholar]
[8]. Tzelepi E, Gaikkoupi P, Sofianou D, Loukova V, Kemeroglou A, Tsakris A, Detection of extended spectrum β-lactamases in clinical isolates of Enterobacter Cloacae and Enterobacter aerogenesJ Clin Microbiol 2000 38(2):542-46. [Google Scholar]
[9]. Clinical and Laboratory Standards InstitutePerformance standards for antimicrobial susceptibility testing; nineteenth informational supplement M100-S19 2009 Wayne, PAClinical and Laboratory Standards Institute [Google Scholar]
[10]. Paterson DL, Bonomo RA, Extended spectrum β-lactamases: a clinical updateClin Microbiol Rev 2005 18(4):657-86. [Google Scholar]
[11]. Black JA, Moland ES, Thomson KS, AmpC Disk Test for detection of plasmid-mediated AmpC β-lactamase in Enterobacteriacae lacking chromosomal AmpC β-lactamaseJ Clin Microbiol 2005 43(7):3110-13. [Google Scholar]
[12]. Dhillon RHP, Clark J, ESBLs: A Clear and present DangerCrit Care Res Prac 2012 [Google Scholar]
[13]. Grover SS, Sharma M, Chattopadhya D, Kapoor H, Pasha ST, Singh G, Phenotypic and genotypic detection of ESBL mediated cephalosporin resistance in Klebsiella pneumoniae: emergence of high resistance against cefepime, the fourth generation cephalosporinJ Infect 2006 53:279-88. [Google Scholar]
[14]. Lal P, Kapil A, Das BK, Sood S, Occurrence of TEM and SHV gene in extended spectrum β-lactamases (ESBLs) producing Klebsiella spp. isolated from a tertiary care hospitalIndian J Med Res 2007 125:173-8. [Google Scholar]
[15]. Goyal A, Prasad KN, Prasad A, Gupta S, Ghoshal U, Ayyagari A, Extended spectrum β-lactamases in Escherichia coli and Klebsiella pneumoniae and associated risk factorsIndian J Med Res 2009 129:695-700. [Google Scholar]
[16]. MacKenzie FM, Miller FM CA, Gould IM, Comparison of screening methods for TEM and SHV derived ESBL detectionClin Microbiol Infect 2002 8:715-24. [Google Scholar]
[17]. Paterson DL, Ko WC, Gottberg A, Cassellas JM, Mulazimoglu L, Klugman KP, Outcome of cephalosporin treatment for serious infections due to apparentely susceptible organisms producing extended spectrum β-lactamases, Implications for the clinical microbiology laboratoryJ Clin Microbiol 2001 39:2206-12. [Google Scholar]
[18]. Wong BA, Therapeutic challenges associated with extended spectrum β-lactamase producing E. coli and Klebsiella pneumoniaePharmacotherapy 2001 21:583-92. [Google Scholar]
[19]. Rice LB, Jao JD, Efficacy of different β-lactams against an ESBL producing Klebsiella pneumoniae strains in the rat intra abdominal abscess modelAntimicrob Agents Chemther 1991 35:1243-44. [Google Scholar]
[20]. Jacoby GA, Sutton L, Properties of plasmids responsible for production of extended spectrum β-lactamasesAntimicrob Agents Chem 1991 35:164-69. [Google Scholar]
[21]. Paterson DL, Mulazimoglu L, Cassellas JM, Ko WC, Goossens H, von Gottberg A, Epidemiology of ciprofloxacin resistance and its relationship to extended spectrum β-lactamase production in Klebsiella pneumoniae isolates causing bacteremiaClin Infect Dis 2000 30(3):473-78. [Google Scholar]
[22]. Gupta V, Singla N, Chander J, Detection of ESBLs using third and fourth cephalosporins in double disc synergy testIndian J Med Res 2007 126:486-87. [Google Scholar]
[23]. Parveen RM, Harish BN, Parija SC, Emerging carbepenem resistance among nosocomial isolates of Klebsiella pneumoniae in South IndiaInter J Pharm Bio Sci 2010 1(2) [Google Scholar]
[24]. Gold HS, Moellering RC, Drug therapy: Antimicrobial-drug resistanceN Eng J Med 1996 335:1445-52. [Google Scholar]
[25]. Tzouvelekis LS, Vatapoulos AC, Katsanis G, Tzelepi E, Rare case of failure by an automated system to detect extended spectrum lactamase in a cephalosporin resistant Klebsiella pneumoniae isolateJ Clin Microbiol 1999 37(7):2388 [Google Scholar]
[26]. Kader AA, Angamuthu KK, Kamath KA, Zamon MN, Modified double-disc test for detection of extended spectrum β-lactamases in Escherichia coli and Klebsiella pneumoniaeBr J Biomed Sci 2006 63:51-54. [Google Scholar]
[27]. Khan MKR, Thukral SS, Gaind R, Evaluation of a Modified Double- Disc Synergy Test for Detection of Extended Spectrum β-Lactamases in Ampc β-Lactamase-Producing Proteus mirabilisIndian J Med Microbiol 2008 26:58-61. [Google Scholar]
[28]. Dhara M, Disha P, Sachin P, Manisha J, Seema B, Vegad MM, Comparison of various methods for the detection of extended spectrum β-lactamases in Klebsiella pneumoniae isolated from neonatal intensive care unitNational J Med Res 2012 2:348-53. [Google Scholar]